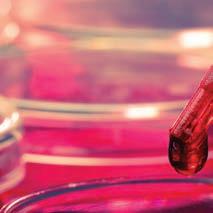

2023
COVER: Cardiac patient Michelle MacDonald. Story on page 8.
ABOVE: Learn about the The Miriam’s newly licensed Nurse Residency Program on page 15.


Welcome to The Miriam Memo! We are always excited to bring you the latest edition of this publication and share important news about the beloved hospital your generosity supports. This time, however, we are even more “amped up” than usual, as the energy of our fabulous Welcome to South Beach-themed gala is still with us in spirit. In these pages, we relive that special evening and thank all our sponsors and friends who made the magical night possible.
Historically, The Miriam Gala & Auction fund-a-needs have supported cancer services. But this year, it was exciting to highlight the Women’s Cardiovascular Program and to raise critical funds for lifesaving technology that will make The Miriam the only hospital in Rhode Island to use groundbreaking diagnostic imaging to detect coronary artery abnormalities unique to women.
This issue also includes a Q&A with Lifespan’s new president and CEO, John Fernandez, as well as stories about grateful patients, next-generation research, and innovative care programs.

Of course, a major reason we are able to talk about all the good things happening at The Miriam is because good people—like you—make them possible. Your donations sustain us, and we are eternally grateful for your extraordinary commitment to The Miriam.
With deepest appreciation,

As part of Lifespan, the state’s largest academic health system, The Miriam Hospital is deeply committed to the triple aim of maintaining excellence in clinical care, education, and research. Doing so keeps our patients at the heart of everything we do and enables us to meet our overarching mission of Delivering health with care to the community we serve.


Your extraordinary support helps to bolster and advance this important work and allows The Miriam to touch more lives and realize better outcomes. And for that, I am forever grateful.
With appreciation,
3
Maria P. Ducharme, DNP, RN President, The Miriam Hospital
Susan H. Kaplan Chair, The Miriam Hospital Foundation Board of Trustees
Susan H. Kaplan
Lawrence A. Aubin, Sr. Chairman, Lifespan Board of Directors Chairman, The Miriam Hospital Board of Trustees
Maria P. Ducharme, DNP, RN
Lawrence A. Aubin, Sr.
ANNUAL GALA & AUCTION RAISES $930,000
More than 450 donors, friends, and supporters of The Miriam Hospital gathered at the 2023 Gala & Auction, which took place Saturday, April 29, at the WaterFire Arts Center in Providence.



Inspired by the passion and creativity of gala chairs, CeCe Bazar Aparo and Michael J. Sweeney, and powered by the e orts of their fabulous sponsorship and event committees, the venue was transformed into one of America’s most unique and premier destinations for one night only.
The Welcome to South Beach-themed soiree featured choreographed dance performances, high-energy party music, spot-on beach and nightlife décor, and a delicious assortment of foods and drinks.
But the true star of the show was the cause itself: raising $930,000 to help support and advance the world-class, compassionate care the hospital delivers to the community it serves, including the evening’s fund-a-need.
Thanks to donors eager to help bring groundbreaking and lifesaving technology to the Women’s Cardiovascular Program at The Miriam—making it the only program in Rhode Island to use state-of-the-art diagnostic imaging to detect coronary artery abnormalities unique to women— the evening’s auctions, spirited fund-a-need, and ra e raised $440,000.
In their respective remarks, Susan H. Kaplan, Chair of The Miriam’s Foundation Board of Trustees, and Maria P. Ducharme, DNP, RN, President of The Miriam Hospital, both praised the hospital’s sta of dedicated caregivers and talked about how their e orts are being augmented by advanced technologies, which are helping them realize amazing patient outcomes.
4
THE
GALA & AUCTION
L-R: Athena Poppas, MD, Michael J. Sweeney, CeCe Bazar Aparo, Susan H. Kaplan, and Maria P. Ducharme, DNP, RN
Dr. Katharine French, Michelle MacDonald, and family
Jenna Rose and her father, David Rampone
Moreover, they added, this lifesaving work is made possible thanks, in large part, to the hospital’s generous and caring donor family. “Philanthropy is not only the key,” Dr. Ducharme pointed out from the podium, “but also what continues to set us apart as a hospital of excellence.”
The evening also featured a moving story from Michelle MacDonald, a grateful patient, who shared her harrowing experience surviving a heart attack caused by spontaneous coronary artery dissection. You can read about Michelle’s journey, which underscores the need to increase awareness about women’s cardiac disease—the leading cause of death for women in the United States—and its unique and often nontraditional symptoms, on page 8.
Sponsorship and ticket sale proceeds from the event bene t

The Miriam’s Greatest Needs Fund for a New Generation, which provides resources to support patient care services, educational programs, and innovative research projects.
The Miriam Hospital extends its sincere gratitude and appreciation to everyone who helped make the 2023 Gala & Auction possible, including their generous sponsors, auction donors, and entire donor community.





Title Sponsor



5
Bert and Margaret Lederer, Arnold and Jane Bromberg, Gale Aronson-Hawkes
Auction fun
Hearts, Minds, and Rhythm, a Lifespan physician band
Evening entertainment Auctioneer Harry Santa-Ollala
Lung Screening and Nodule Program

Dollars raised from the 2022 Miriam Hospital Gala & Auction fund-a-need were targeted for the creation of The Lung Screening and Nodule Program at The Miriam Hospital, which o cially opened April 7, 2023. The program brings together recognized leaders and specialists in a range of disciplines who provide the expertise and coordinated care necessary to meet the speci c needs of each patient, beginning the moment a potentially cancerous lung nodule or mass is detected.
“Lung cancer is still the leading cause of cancer death in the United States, claiming the lives of more men and women each year than colon, breast, and prostate cancers combined,” explains Hina Khan, MD, a medical oncologist at The Miriam. “Early detection is critical to successful treatment, and now patients in southeastern New England have access to a rst-of-its-kind clinic dedicated exclusively to this speci c care.”
Dr. Khan adds that a Nodule Tumor Board is also planned as part of the clinic’s work. The board will convene to discuss each case with the multidisciplinary team—comprised of pulmonary, radiology, thoracic surgery, radiation oncology, and medical oncology experts—and o er relevant recommendations. Additionally, the clinic’s work will complement Lifespan Cancer Institute’s ongoing research focusing on lung cancer screening in underserved populations. For more information, please call 401-793-3338.
Center for Innovative Cancer Research
In 2021, The Miriam Hospital Gala & Auction fund-a-need supported the creation of the Stephen and Diana Lewinstein Center for Innovative Cancer Research at The Miriam Hospital.
The new center, which held its “open house” May 23, 2023, establishes The Miriam as a leading provider for advanced, highly novel cancer treatments—giving hope to patients whose cancers have advanced, despite receiving all standard treatments, and are searching for the most advanced options to extend their lives.
“Opening the center has ignited a new trajectory for oncology care at The Miriam,” says Benedito A. Carneiro, MD, Director of the Clinical Research, Cancer Drug Development, and Associate Director of Division of Hematology/ Oncology. “It represents the cornerstone of an exciting and rapidly growing program and expands The Miriam’s reputation for providing cutting-edge cancer care—enabling us to become a regional referral hub for new drug development, where patients will have access to promising new treatments.”
A recent example was the center being able to treat a patient with one of the most promising immunotherapies for prostate cancer in the world.

6 PHILANTHROPY IN ACTION
MEET LIFESPAN’S NEW PRESIDENT AND CEO: JOHN FERNANDEZ

Working hard behind the scenes since his appointment was announced, John Fernandez hit the ground running when he o cially started as President and CEO of Lifespan on January 30. He brings more than three decades of health care leadership experience to his new role, most recently, as President of Mass Eye and Ear in Boston.
As he continues to meet the community, donors, and sta , he recently answered a few questions to help everyone get to know him.
What do you want people to know about you and what you bring to Lifespan?
One of the key qualities of my leadership style is to recognize and value the talents of our team. I’ve been so impressed with the commitment and talent I’ve seen so far at Lifespan—it’s one of the things that brought me to Rhode Island. I also talk a lot about kindness. It’s the foundational part of great teams. When building a team, I often say I hire for kindness, which sometimes stumps the most hard-charging and achievement-oriented candidates. Kindness, teamwork, and getting stu done are what people often remember most about me. I look forward to working with great teams to get stu done here at Lifespan.
What are your main areas of focus at Lifespan?
We’re working on improving our nancial, operational, and quality performance. This includes focusing on a reduction in length of stay, expanding services and increasing access for patients, championing diversity, equity and inclusion, and retaining and recruiting more employees to work at Lifespan. Working together, with employees, the community, and our generous donors, I know we can leverage the tremendous talent, intellect, generosity, and kindness to realize Lifespan’s most ambitious goals and plans.
How do you see philanthropy supporting and driving Lifespan’s mission of Delivering health with care ?
Philanthropy is critical to driving Lifespan’s mission into the future. At all locations, including The Miriam Hospital, it helps cover the costs for providing millions of dollars of care each year for those individuals who are unable to pay, as well as strengthening the organization and helping us become a destination for health care services, not only in Rhode Island and New England, but nationally. While all philanthropy is important, strategic philanthropic investments in priority areas are what will help get us to the next level. Key to this is continuing to build a culture of philanthropy and physician partnerships as well as fostering gratitude from patients and family members after receiving care. I’m con dent we are just at the beginning of realizing the potential of philanthropy for the bene t of our patients and the community.
7
John Fernandez
WOMEN’S CARDIAC EXPERTISE AT THE RIGHT TIME
From the moment I saw the sunrise after my surgery, I knew I had to live this life di erent,” says Michelle MacDonald, recalling the morning after she su ered a “widow making” cardiac event.

Michelle, a very active mom, wife, and rst-grade teacher, was the last person anyone would suspect to have a cardiac condition—even her PCP. But, the symptoms she was experiencing for a few weeks prior to that fateful date in September 2022, were symptoms of a heart condition.
“I wouldn’t say that I ignored symptoms, but I didn’t exactly know what to look for,” she explains and describes being a little out of breath and rubbing her chest after a walk. “It felt like I worked out too hard or that it was heartburn because it didn’t register as pain.” She also had jaw pain—a common but often unknown heart attack symptom in women—but didn’t connect the dots because she had no risk factors for cardiac disease.
Thankfully, she didn’t ignore her watch’s alert that her resting heart rate was high and called 911.

“If my husband had been at work that evening, I would have just gone to bed hoping to feel better in the morning,” Michelle says, “but I probably wouldn’t have woken up.”
Emergency responders brought her to the emergency department at The Miriam Hospital, where initially, they weren’t sure what was happening, but attending physician Taneisha Wilson, MD, reassured her she was in the right place.
Michelle was having a heart attack, but the cause was not a common cholesterol blockage. She had a condition called SCAD—spontaneous coronary artery dissection—where the lining to the artery tears and causes a blockage. It mostly a ects women in their 40s and 50s without the common cardiac risk factors such as high blood pressure, high cholesterol, or
8
“
“I really, truly believe that The Miriam gave me a second chance and I am grateful. ”
—Michelle MacDonald
diabetes. For Michelle, the symptoms she had been experiencing were a result of tearing vessel and the slowing of blood ow, ultimately blocking the artery and causing her heart attack.


By the time Michelle reached the cardiac cath lab, her artery was 98 percent blocked.
With his experience and expertise, interventional cardiologist Douglas Burtt, MD, placed two stents to clear the blockage. Dr. Burtt explains, “we don’t always place stents for SCAD but in Michelle’s case it was our best option to restore blood ow.”
Initially it was thought she could go back to work as a teacher, but upon meeting with Katharine French, MD, Director of the Women’s Cardiac Center, it was recommended that Michelle allow her body time to heal. “My job as a rst-grade teacher is anything but sedentary, so going to cardiac rehab was an important step in getting me back to physical activity in a safe way,” says Michelle.
“We don’t have any data to suggest that physical activity increases the risk of her having another SCAD event. However, those older perceptions that all activity is bad and increases your risk for SCAD still permeate amongst the community and professionals. It’s really important to have a team caring for her that understands that there’s no data to suggest that she now can’t exercise,” explains Dr. French.
Today, Michele is back in the classroom and enjoying an active life, while following doctors’ orders, and taking nothing for granted.
“I’m so grateful for my family, my friends, and my school community for all their support along this journey. I take every opportunity to educate people about heart health and don’t let any opportunity pass me by,” says Michelle. “I really, truly believe that The Miriam gave me a second chance and I am grateful.”
To watch Michelle tell her story, visit: giving.lifespan.org/The-Miriam/2023-Gala-videos
9
Dr. Katharine French and Michelle MacDonald
Michelle with her husband Fred and three daughters
SELYAS’ GENEROSITY FUNDS NEW EMPLOYEE WELLNESS CENTER
the First Circuit, and his wife, attorney Cynthia M. Selya. Recently, the couple donated $300,000 to help establish a dedicated employee wellness center on The Miriam campus.

“We are, in our hearts, Miriam people,” Bruce says, “and it’s our hospital of choice. The incredible people who work there deserve all the praise and plaudits we can give them. If creating this wellness center makes their lives a little easier, we’d consider that a labor of love.”
COVID-19 was challenging on so many levels and for so many people. But health care workers may have borne the brunt of the pandemic’s unrelenting wrath. Day after day, doctors, nurses, and essential support personnel literally put their lives on the line to help others while simultaneously ignoring the very real toll the job was taking on themselves physically, mentally, and emotionally.
“As caregivers, we’ve always understood how rewarding and meaningful our work is, and also how stressful and demanding it can be,” explains Maria P. Ducharme, DNP, RN, President of The Miriam Hospital. “But the weight and magnitude of the last few years has put the issue of health care employee wellness front and center, which is where it belongs.”
Dr. Ducharme says that while The Miriam has proudly maintained a people- rst work culture for decades, it will soon level-up their commitment to sta in a bold way, thanks to the generosity of longtime supporters and advocates, The Honorable Bruce M. Selya, Senior U.S. Circuit Judge, United States Court of Appeals for
Cindy adds, “The gift is our way of saying ‘thank you’ to the people who sel essly take care of our community. Hopefully, the center will provide them with the comfort and relief they need to recharge and continue their exceptional work.”
“Our people are our most valuable resource,” echoes Vanzetta James, DNP, Senior Vice President of Patient Care Services and Chief Nursing O cer. “When we invest in their health and well-being, we know that our patients will also bene t from that investment. After all, you can’t take care of others if you don’t take care of yourself.”
Once up and running, the center will provide a comprehensive suite of o erings geared toward supporting employees’ whole-person wellness. Gym standards like weights, cardio equipment, and yoga classes, as well as nonpharmaceutical and integrative therapies like reiki, massage, mindfulness, transcendental meditation, and guided imagery are all in the plans. The center will also house a con dential space for employees seeking support to talk with a counselor.
“The Selyas’ inspired giving turned our vision into reality,” Dr. Ducharme concludes, “and we are so grateful for their support.”
10
Cynthia and Bruce Selya with Maria P. Ducharme, DNP, RN
A GRATEFUL HEART
Like many people, Jill Marinelli and her family knew others with heart disease, but had never experienced its impact rsthand. That changed in 2019 when Jill’s athletic younger brother collapsed while running a 5K. Fortunately, a de brillator saved his life on the scene. However, instantly, heart disease became the center of their world.
Through genetic counseling at The Miriam Hospital, Jill learned she had a variant of the FLNC gene that can cause sudden cardiac death and cardiomyopathy, a disease of the heart muscle that makes it harder for the heart to pump blood to the rest of the body.

“I was terri ed,” Jill recalls, and sought the care of Lifespan Cardiovascular Institute cardiologist Joe Weiss, MD. “When I met Dr. Weiss he told me that the genetic condition I have was only just described in 2016 and there wasn’t a lot of research on it yet, but that I should get an implantable cardioverter de brillator (ICD) in a few months in case I went into sudden cardiac arrest.”
With surgery scheduled, Jill reached out to Dr. Weiss a few weeks later after almost fainting. She didn’t think it was a big deal, but Dr. Weiss told her to go to the emergency department immediately. This time, she wasn’t leaving The Miriam without the ICD.
“I didn’t know The Miriam was the place to go for heart conditions, but I’m so grateful I did,” says Jill. “I’m con dent in the care I received and grateful to get back to living my normal life knowing I have a safeguard in place that will help me be around a long time for my kids and loved ones.”
If you are grateful for the care you or a loved one received, please scan to learn more.
LEAVE A LASTING LEGACY
Planned giving provides donors, like you, with a meaningful opportunity to leave a lasting legacy by supporting The Miriam Hospital and positively impacting the future of patient care for generations to come.
This type of philanthropy—whether you designate The Miriam as a bene ciary of your estate, retirement account, donor advised fund, or life insurance policy—enables the hospital to remain focused, in the long term, on its unyielding pursuit of excellence in the delivery of health care, pioneering research, medical education, and technology.
For more information about planned giving and how it helps advance The Miriam’s lifesaving work, visit us at lifespan.org/TMHLegacy or contact Chris Josephson, Manager of Annual and Planned Giving, at 401-444-6412 or email chris.josephson@lifespan.org.

11
Jill Marinelli
SUPPORTERS HELP THE MIRIAM ACQUIRE INNOVATIVE ULTRASOUND EQUIPMENT
Thanks to the individual generosity of two longtime supporting organizations—The Norman and Rosalie Fain Family Foundation and The Edward J. and Virginia M. Routhier Foundation—
The Miriam recently acquired innovative ultrasound imaging equipment that will help improve patient care in the hospital’s operating rooms. Speci cally, the separate gifts, which totaled more than $220,000, enabled The Miriam to purchase two di erent advanced systems.
One system is designed for general surgical needs, providing real-time ultrasound imaging with speci c features to enhance surgical decision-making and adapt surgical plans while in the operating room. For example, it can help verify the exact location of a tumor, accurately depict its size, and con rm the placement of surgical instruments all in real-time while a procedure is ongoing.
Similarly high-performing and versatile, the second system will be dedicated to providing enhanced capability for urology procedures, including brachytherapy, a cutting-edge technique to treat cancer, especially prostate cancer, by inserting radioactive implants directly into the tissue.
“These ultrasound systems feature the latest technology available, and both allow The Miriam to further its o erings of minimally invasive surgical procedures,
which are both quicker to perform and signi cantly reduce a patient’s overall treatment time,” explains Sheila Capasso, Director of Operating Rooms, Administrative Support, and Surgical Services at The Miriam.
These days, minimally invasive procedures are in high demand because they allow patients to return to their lives with little interruption. Also, they are often conducted on an outpatient basis and do not require inpatient admission—allowing hospitals to surgically treat more patients than they could otherwise serve.

Without the newly acquired pieces of invaluable equipment, Sheila concedes, “many of our patients would likely need to travel to Boston to receive similar care—which is why these donations are so very important.”
Re ecting on the latest gifts, Sheila, who has worked at the hospital since 1980, says she is blown away by the continued support the two donating organizations have shown The Miriam over the years.
“I think it speaks volumes about their philanthropic generosity,” she says. “Even in this day and age, with the cost of everything escalating as it is, they see the value in what we do here at The Miriam and how much we mean to the community. So, they are always there for us, and we are greatly appreciative.”
12
LOYAL DONOR ENDOWING INNOVATIVE HODGKIN’S LYMPHOMA RESEARCH





Michael Savit is a generous supporter of The Miriam. Since 2002, he and his family have sponsored the HWS Golf Classic, an annual charity tournament that has raised approximately $2 million for the hospital’s research to nd a cure for myelo brosis—a rare blood cancer that took his father’s life in 1995. To honor his legacy, Michael, his brother, Je rey, and their mother, Sybil, established the Herbert W. Savit Research Fund.
Now, more than two decades later, he’s endowing di erent research also inspired by a family member’s health crisis. “My son, Matthew, 31 at the time, was diagnosed with Hodgkin’s lymphoma in 2021,” Michael explains. “Fortunately, he’s been treated, his cancer has been in remission for a year-and-a-half, and he’s doing great. But the experience really hit home for me and my family.” So much so, Michael began to look for ways he could help in the ght against this complex cancer of the immune system that can often a ect younger people, like his son.
For Michael, Managing Partner of the HWS Group, a sports management rm that owns and operates professional sports franchises, that meant teaming up with The Miriam once again—this time, with Thomas Ollila, MD.
A hematologist-oncologist with a focus on lymphoma, including clinical and translational research, Dr. Ollila is currently engaged in early-stage but promising work at The Miriam. He is collaborating with the Brown University-based Bailey Lab, which studies the role of genetic variation in immunity and disease. The goal: to develop a novel technique for nding and tracking Hodgkin’s lymphoma.
“We know you can nd DNA for Hodgkin’s lymphoma in the blood,” Dr. Ollila says, “and by identifying and tracking it earlier and with more precision, we’ll be better able to
employ more targeted immunotherapies and o er much safer treatment options.”








On the latter point, Dr. Ollila says his research is intended to combat the “over-treatment” of patients by reducing their need for biopsies, chemotherapy, and PET scans.
All are proven to be valuable and e ective, he says, but can also come with serious side e ects—heart damage, increased risk of infection, neuropathy, and infertility, to name a few.
In his research, Dr. Ollila is using molecular inversion probes as a sequencing approach to locate and identify genes in the blood associated with Hodgkin’s lymphoma—and he’s grateful for the philanthropy that’s helping to fund his mission.
“Michael’s gift is making our work possible by covering the upfront cost of the probes and other integral supplies,” he says, “and will help us save lives down the road.”
Michael encourages others to support The Miriam, too. “If you have the means, by all means you should,” he says. “You won’t be disappointed. The people at The Miriam have been great to work with for over 20 years now and you’ll be helping a lot of people.”
13
MIRIAM PHYSICIAN RESEARCHER APPOINTED AS ENDOWED CHAIR
Thanks to the incredible generosity of two longtime, active supporters of The Miriam Hospital—who wish to remain anonymous at this time—a new endowed professorship in translational medicine has been established at The Warren Alpert Medical School of Brown University. Christopher Gerard Azzoli, MD, a physician-researcher at The Miriam who serves as Director of Thoracic Oncology for the Lifespan Cancer Institute, has been named to ll that role.
Dr. Azzoli is a medical oncologist who specializes in the care of patients with lung cancer, mesothelioma, and thymoma (cancers of the chest), and conducts clinical trials of new drugs for patients with lung cancer. An important focus of his research is to develop blood tests that may detect when an immune stimulating drug, or treatment, has triggered bene cial immune activity in his patients.
Bench to bedside
Translational medicine is often referred to as “benchto-bedside,” or “bedside-to-bench.” This is the process by which observations in the clinic directly impact a laboratory experiment, or vice versa. Translational science is a discipline within biomedical and public health that essentially “translates” results into new therapeutics, diagnostic tools, medical procedures, and so much more.
“Our goal is to bridge the divide between two worlds: the world of clinical care and the world of laboratory research,” Dr. Azzoli explains. “Professorships like this are transformational gifts which allow us to close the gap between what we can do in the laboratory, and how we practice medicine.” In the most immediate term, Dr. Azzoli’s thoracic oncology team will be using the funds, in part, to support biomarker studies that will measure immune response in cancer patients receiving state-of-the-art, and experimental immune-stimulating treatments. He says these resources will enable him to collect blood and tissue and use it in innovative ways beyond routine pathology, such as studying the white blood cells in the tissue, or components of blood, to detect immune activity, which is novel and could lead to discovery.
Philanthropy is the ‘engine’
“This gift provides us the freedom and the resources to really chase down new ideas and make discoveries that, ultimately, will lead to better treatments and diagnostic tests,” Dr. Azzoli says. “We simply would not be able to do this work without the donors’ amazing support, vision, and care. They are the engine.”

For their part, the unnamed donor couple are just pleased to be making a di erence:
“We’ve worked hard and been lucky in life and wanted to share our good fortune with the community through this gift. Our involvement with and appreciation of The Miriam led us to exploring what we might accomplish for the hospital that was important to us and to the people of this state; the idea being to establish something that didn’t exist previously and would have a lasting impact.”
14
Dr. Christopher Gerard Azzoli
FAMILY’S PHILANTHROPY HELPS MOLD NEXT GENERATION OF NURSES
The Miriam’s excellence in nursing is nearly impossible to overstate. Now, a new residency program is among just a handful of programs in the world to achieve Practice Transition Accreditation.
“We are nationally recognized and the only accredited program in Rhode Island—you come here to learn from the best,” says Melanie Marco, MSN, APRN, AGCNS-BC, NPD-BC, manager of The Miriam’s Newly Licensed Nurse Residency Program (NLNRP).
A yearlong program, the NLNRP provides newly licensed nurses the clinical experiences that hone the skills they need to deliver the highest quality of care. The Miriam’s program is accredited by the American Nurses Credentialing Center, and philanthropy has helped to build it into what it is today.
Through the generosity of the Kilmartin family, NLNRP is supported with resources that enable it to meet emerging educational needs and provide innovative learning opportunities. The family established The David, Betsey, and Kelly Kilmartin Nurse Residency Endowment from a charitable trust David and Betsey created when they married 50 years ago.
David, who passed away in 2017, grew up blocks from the hospital he would rely upon throughout his life and that would later save his wife’s life. Their daughter, Kelly, is a nurse.
“The Kilmartin family’s support is an incredible blessing,” Melanie says. “They want to help the program with whatever we need to train the best nurses possible.”
One of those needs presented as a result of the pandemic and nursing students’ inability to enter hospitals for some clinical courses. As this led classes of nurses everywhere to graduate with less clinical experience than previous years, The Miriam brought
simulation to its new nurse hires.
And the Kilmartin’s endowment helped make it possible.
On a regular schedule, Lifespan sets up a Medical Simulation Center at The Miriam. In this realistic training environment and under the direction of specialized technicians, new nurses test their mettle on state-ofthe-art manikins connected to computers to mirror realworld medical situations. They breathe, blink, and obey commands delivered electronically. Depending on the exercise, nurses might administer an injection, place a de brillator, or apply oxygen. Based on nurses’ actions, the ‘patient’ may improve, or get worse.
“This o ers real-time feedback on how nurses are performing,” says Melanie. “To be able to go through di erent scenarios and work on emergency response in a controlled way is invaluable. It’s amazing, really.”
And the proof, as they say, is in the pudding.
Not only is nurses’ feedback on simulation overwhelmingly positive, but it’s also impacting patient care and helping to drive retention. Over the past year, 90 percent of The Miriam’s new nurse hires remain at the hospital, a much higher mark than the national average of 67 percent.
“We’ve created a culture that supports the success of new nurses,” Melanie adds. “Every day I consider myself lucky that this is my job and that I’m helping nurses to grow.”

15
Tayla Dicarlo, BSN Melanie Marco, MSN, APRN, Kayla Hogan BSN, Shanon Farrell, BSN
If you do not wish to receive mail solicitations from The Miriam Hospital, or from other Lifespan institutions, please email privacyofficer@lifespan.org, call 866-626-0888 or 401-444-6500 and leave a message, or write to Lifespan Compliance & Privacy Office, 245 Chapman Street, Suite 200, Providence, RI 02905

SUPPORTER SPOTLIGHT: CUSTOMERS BANK

Aleader in the banking industry for its breadth of services and personalized approach, Customers Bank is also tops when it comes to giving back to the community.

The bank’s charitable giving priorities focus on children’s initiatives, education, veterans’ programs, community development, and health care. Falling into the latter category, Customers’ support of The Miriam is attributed to a pair of senior executives, Steve Issa and Mike Solomon, with strong local ties and a deep appreciation for their hometown hospital.
“Customers may be headquartered in Pennsylvania, but our o ce is in Providence and our employees and their families are all from this area,” Steve explains. “We are big believers in the power of philanthropy and especially in supporting The Miriam— because it’s such a special place.”
Steve was New England Regional President of Customers Bank until retiring recently and transitioning that role to Mike. Over the years, Steve has demonstrated his active support for The Miriam in a variety of ways. He serves as Vice Chair of The Miriam Hospital Foundation Board of Trustees, as well as Chair of
the Corporate Sponsorship Committee. Thanks to Steve’s connections and e orts, Customers has been a loyal donor to The Miriam for more than a decade, and corporate sponsorships for the hospital have grown exponentially. On a personal level, Steve has generously supported The Miriam for nearly two decades.
Mike, who considers Steve a mentor, shares a similar passion. “It’s always been an easy ask for us to support The Miriam and get other companies to support them as well,” he says, “because everyone knows the value of The Miriam.”
To prove the point, he shares an anecdote from this year’s Gala— an event Customers sponsored. “The co-chairs asked the audience ‘Who here has received care at The Miriam or has had a family member or friend receive care there?’ Every hand in the room went up,” Mike says. “When people are in a vulnerable position or facing a health crisis, they always remember who was there for them . . . and that’s why we always need to be there for The Miriam.”
with our donors electronically. If you’d like to receive timely updates by email and
postage costs, please email TMHGiving@lifespan.org.
contacting the Development O ce at 401-793-2004 or visit lifespan.org/TMH-giving.
NONPROFIT ORG. U.S. POSTAGE PAID PROVIDENCE, RI PERMIT NO. 538 PO Box H Providence, RI 02901
e Miriam Memo, a
of e
and
At times we share news and information
us reduce paper and
We
you to learn more
publication
Miriam Hospital Foundation, is published for our friends
supporters.
help
invite
by
Mike Solomon and Steve Issa